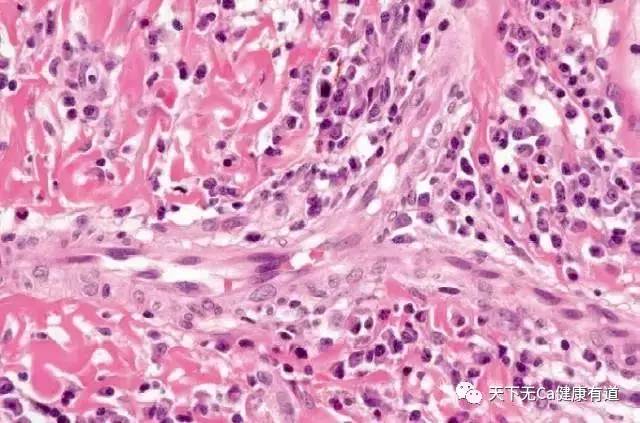
怎么判断升白针是否有效,升白针都有哪种

升白针主要作用原理
刺激骨髓造血细胞加快速度生成白细胞,以维持机体的免疫。如果病人长期应用升白针,会很容易造成骨髓造血细胞的“疲劳”,一旦停止升白针,反而无法维持正常的免疫力。就好比过度征召童子军去打仗一个道理。

升白针最明显的副作用
会引起骨头酸痛,这是过度加快骨髓造血细胞生产白细胞的缘故。一般停止打升白针一段时间后缓解。
化疗后引起的骨髓抑制主要表现为白细胞的降低,以粒细胞降低为主,升白针造成的白细胞的急剧增高仅仅是一个调动骨髓后产生的现象,停药后会逐渐降至正常,不要太担心,对身体也不会有太大的影响。只是,下次记得打升白针的过程中要监测血象,一般打到白细胞达一万以上即可。
在肿瘤化疗过程中,因为化疗药物抑制骨髓造血,导致白细胞下降,有时甚至可以使白细胞数降至500个每微升,这时就被称为粒细胞缺乏期,这样的时期会导致机体免疫力严重下降,可能继发肺部、肠道、口腔、肛周粘膜等部位感染,是化疗最普遍也是最严重的毒副作用。

为了尽快恢复骨髓的造血功能,临床上应用骨髓造血集落刺激因子(G-CSF)来刺激骨髓快速造血,其中提升白细胞的针剂应用比较普遍。
一般在化疗的大概第十天左右,骨髓抑制最严重,然后造血功能开始恢复。在初始使用升白针时没有什么感觉,有时皮下注射一到两次,每次可以用到300微克,连续几天打针后,这时骨髓造血加速,由于细胞的快速增长,病人可以明显感觉不适。
主要表现为整个脊柱,特别是腰骶部胀痛,有时是搏动性的抽痛,这种感觉是非常明显而且难以承受的,仿佛里面有锥子在钻一样,连直起腰都很困难,此时只能躺着不动,要是你试图坐起来,是一定会痛到尖叫的。
经常会听到病房里有人因为这样而痛苦*吟呻**,或是在床上翻滚。疼痛也常发生在双髋部、双肩部等骨髓造血活跃的部位,一般会持续2到3天,逐渐缓解。
当疼痛来临的时候,建议无需忍痛,忍受意味着痛苦体验的加深,而且无法安心休息,不利于病情恢复。建议轻的可以口服芬必得,或是西乐葆;较严重的口服曲马多胶囊;再严重的,干脆注射杜冷丁或者*啡吗**,为止短痛而短时期应用时,这些药物不至于成瘾。
临床上常用升高白细胞药物有:维生素B4、利血生、鲨肝醇、辅酶A等,一般无任何副作用。患者可在医生指导下酌情选用。

白细胞减少症和粒细胞缺乏症
白细胞减少症和中性粒细胞缺乏症都是由于各种病因引起的一组综合征。根据其临床特点,属于中医学\"气虚\"症范畴。
临床表现
白细胞减少症:一般有头晕,乏力,四肢酸软,食欲减退,低热,失眠等非特异性症状。少数无症状,部分病人则反复发生口腔溃疡、肺部感染或泌尿系感染。
粒细胞缺乏症:起病多急骤,常有高热、寒战、头痛、疲乏或极度衰弱。有时口腔、鼻腔、皮肤、直肠、肛门、阴道等黏膜处可出现坏死性溃疡。对药物过敏者,可同时发生剥脱性皮炎,严重者可发生中枢神经系统症状。常迅速发生败血症或脓毒血症而导致死亡。
诊断
白细胞减少症:由各种原因导致外周血白细胞数低于4.0x109/L。儿童的标准为10~14岁低于4.5x109/L,5~9岁低于5.0x109/L,小于5岁低于5.5x109/L。
中性粒细胞减少症和粒细胞缺乏症:外周血中性粒细胞绝对值在成人低于2.0x109/L时称中性粒细胞减少症;低于0.5x109/L时称为中性粒细胞缺乏症。